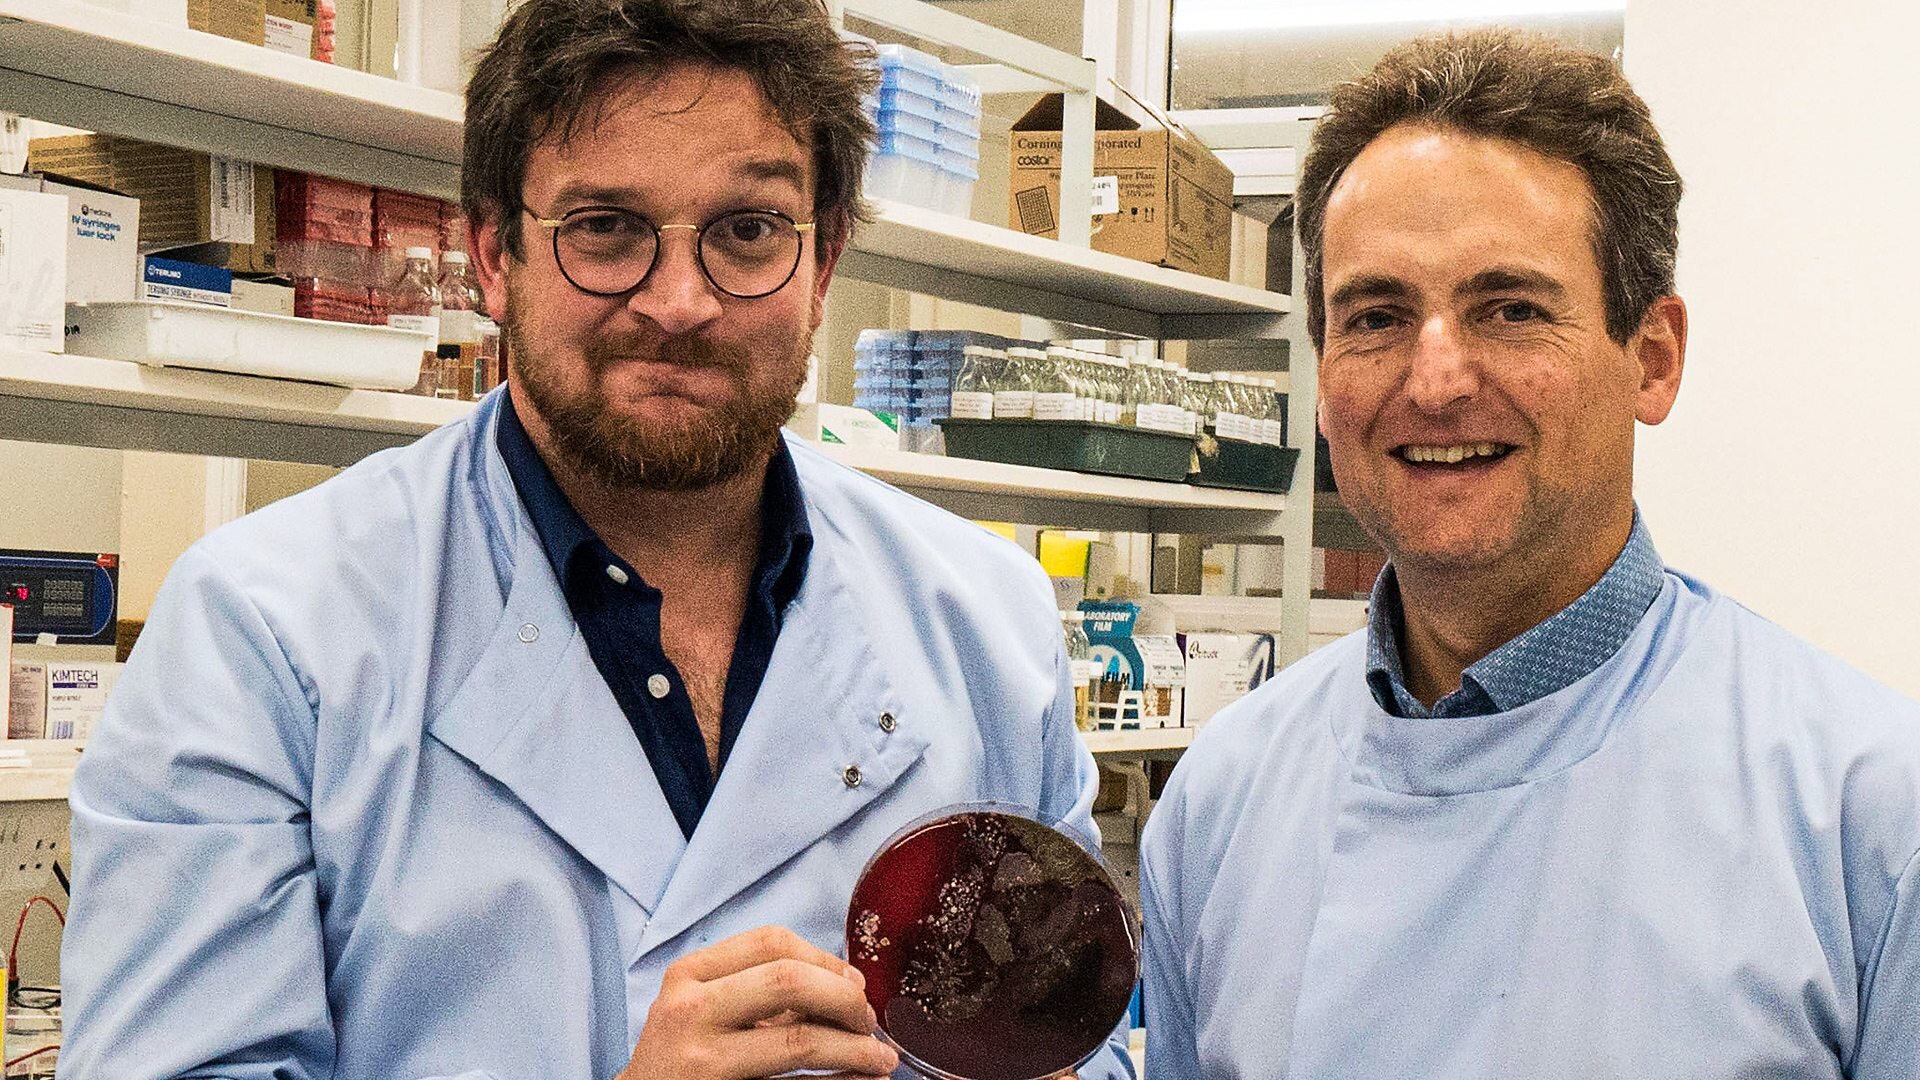

Secrets of Skin S1E3: Protection
- Aired: 2019-12-17
- Time: 19:30:00
- Runtime: 30 minutes
Watch Episode
Overview
Professor Ben Garrod reveals how skin protects vertebrates from extremes of temperature, the harmful effect of UV and a host of living organisms that want to get in.